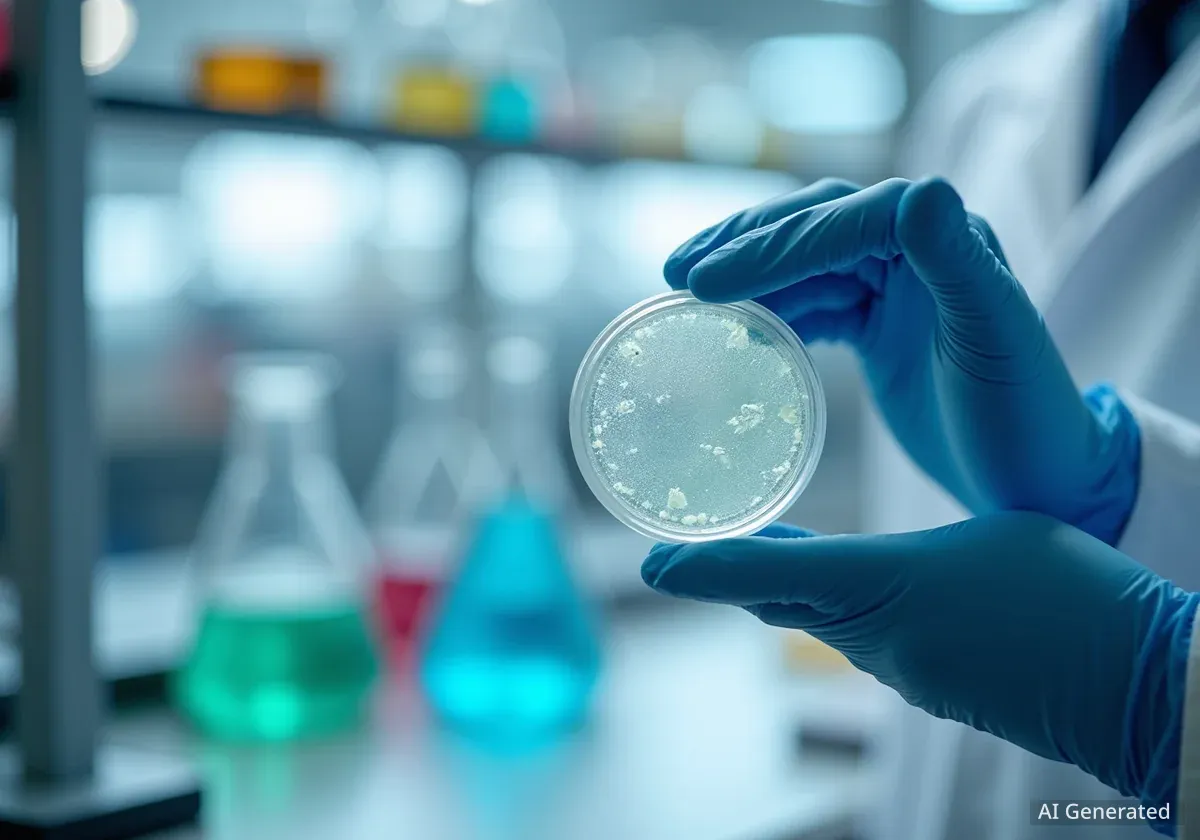
Impacto de la inversión NIH en desarrollo de fármacos

Científicos Mapearán el Sexto Sentido del Cuerpo
Científicos en EE. UU. lanzan un proyecto de 14.2 millones de dólares para crear el primer atlas de la interocepción, el “sexto sentido” que monitorea las señales internas del cuerpo, liderado por el
#Interocepción#Neurociencia#Salud